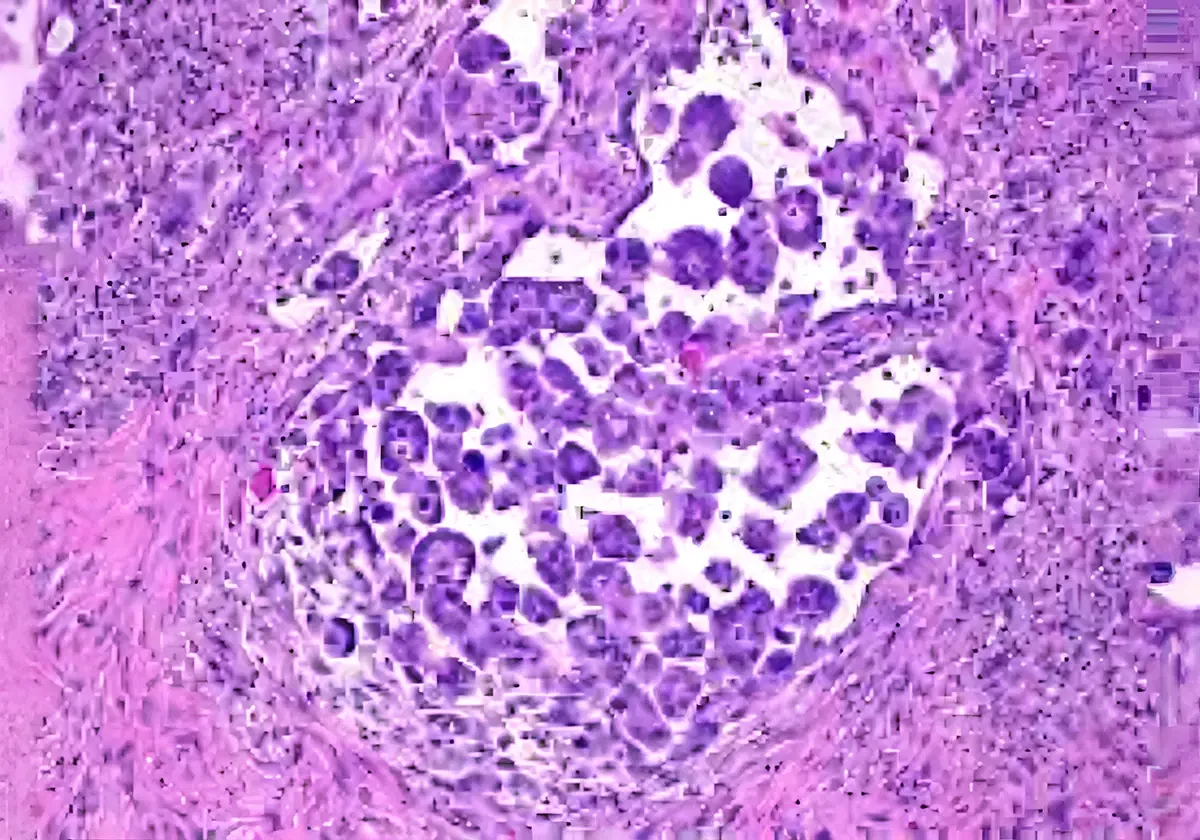

Mesothelioma is an incurable cancer caused by the inhalation of asbestos fibres. Mesothelioma develops in the mesothelium, the thin layer of tissue that covers the internal organs.
It develops when asbestos fibers lodge in the pleura or peritoneum and cause it to form a thickening or mass.
Mesothelioma has a long latency period, where it can take 10-50 years from the time of exposure to when symptoms develop.
There are several different types of mesothelioma, primarily categorized by where in the body they develop. More than 80% of mesothelioma cases affect the lining of the lungs (the pleura), known as pleural mesothelioma. Less commonly it can affect the lining of the abdominal cavity (the peritoneum), known as peritoneal mesothelioma.
Different types of mesothelioma:

Mesothelioma develops when asbestos fibers lodge in the mesothelium, causing it to form a thickening or mass. This triggers an inflammatory process causing fluid to build up.
If this occurs in the pleura (pleural mesothelioma), fluid builds up in the lungs causing pleural effusion, and the lungs no longer function normally. Fluid will need to be drained periodically. Similarly, fluid can build up in the sac that surrounds the heart, causing pericardial effusion.
There are two subtypes of mesothelioma; epithelioid and sarcomatoid. A person can have one or both (biphasic or mixed) subtypes of mesothelioma. The subtype and location of mesothelioma affects the rate at which mesothelioma develops and the effectiveness of treatment.
Exposure to asbestos is the only accepted cause of mesothelioma in Australia. There is no known safe level of asbestos exposure, however, not everyone exposed to asbestos will develop mesothelioma.
There are several factors that can increase the risk of developing mesothelioma. These include:
Mesothelioma can have a variety of symptoms depending on where the cancer is located, the behaviours of the the cancer, the age and underlying health of the individual, and the individual tolerance. Some people have very few or no symptoms. The most common symptoms include:
If you are concerned, you should speak with your GP and advise if you have been exposed to asbestos during your lifetime.
The GP will likely organise Xray's and/or a CT scan and blood tests. If there is a collection of fluid, further investigation may be required and drainage of the fluid carried out where a sample of fluid is sent to pathology for testing.
Sometimes a diagnosis is not able to be made from the pleural fluid. In this case a cardiothoracic surgeon will perform a pleural biopsy where a sample is taken and examined under a microscope.


Website designed by c4 Digital Agency